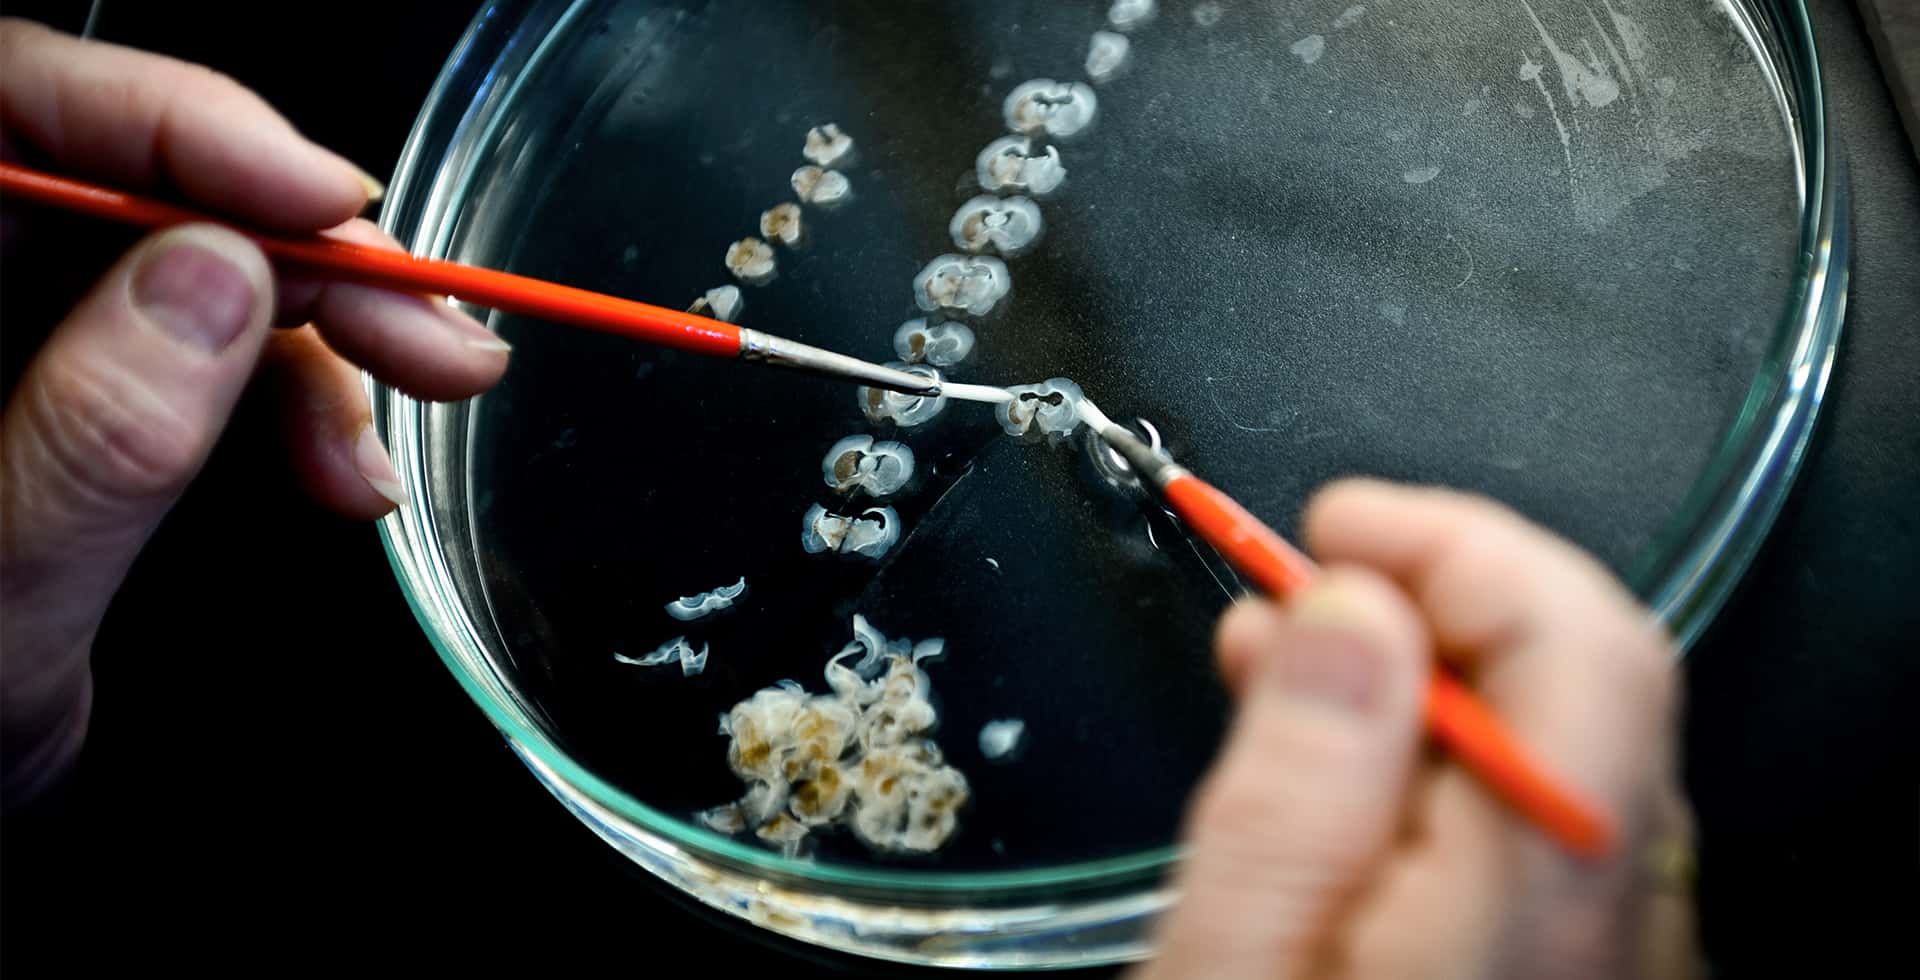
Händer arbetar i en petriskål med fina verktyg.

Stamcellsbehandling av Parkinsons sjukdom – första patienten transplanterad
Stamcellstransplantation som behandling av patienter med Parkinsons sjukdom är på väg att blir verklighet. I februari testades behandlingen för första gången på en patient vid Skånes universitetssjukhus. Tekniken är utvecklad av Malin Parmar och hennes forskargrupp vid Lunds universitet med stöd från Hjärnfonden.
En patient med Parkinsons sjukdom förlorar successivt de nervceller i hjärnan som producerar signalsubstansen dopamin, ett ämne som hjärnan använder för att skicka signaler mellan hjärncellerna och som bland annat behövs för att vi ska kunna röra oss smidigare. Symtomen är skakningar, darrningar, muskelstelhet och sämre balans. Idag finns inget bot mot Parkinsons sjukdom, bara symtomlindrande läkemedel som ersätter förlusten av dopamin, men dessa behandlingar blir över tid mindre effektiva och orsakar besvärliga biverkningar. Det finns inga behandlingar som reparera skadade strukturer eller ersätta de dopaminproducerande celler som bryts ner.
Forskningsgenombrott med transplanterade stamceller
Forskare i Lund hoppas nu revolutionera behandlingen av Parkinsons sjukdom genom att ersätta de förlorade dopamincellerna med friska celler i patientens hjärna. Malin Parmar är professor i cellulär neurovetenskap vid Lunds universitet, hon leder projektet STEM-PD där man nu lyckats styra om labbodlade stamceller till att bli dopaminproducerande nervceller. De här nya cellerna ska fungera som reservdelar som transplanteras in i hjärnan på patienter med Parkinsons sjukdom. I februari startade de första försöken på människor där åtta Parkinsonpatienter får nya dopaminproducerande nervceller. Målet är att ta fram en engångsbehandling som kan bromsa sjukdomens effekter livet ut och projektet beskrivs som en revolutionerande milstolpe i forskningen kring Parkinsons sjukdom.
Malin Parmar, varför är denna behandling så revolutionerande?
– Hela forskningsfältet med transplantation av stamceller är revolutionerande i sig med flera kliniska försök inledda. Just den här kliniska studien är en av de första stamcellsbehandlingarna för Parkinson som testas. För Parkinsons sjukdom hoppas vi att den här behandlingen kan återuppbygga hjärnan på ett sätt som dagens läkemedel, L-dopa till exempel, inte gör.
Nu testar ni behandlingen på Parkinsonpatienter, men kommer den att kunna användas för andra neurodegenerativa diagnoser också?
– Konceptet med att transplantera in nya celler i hjärnan skulle kunna användas för många sjukdomar som karaktäriseras av förlust av nervceller. Jag har till exempel kollegor här i Lund som jobbar med stamcellsterapi för stroke och Huntington. Anledningen till att vi kan göra de första kliniska studierna på just Parkinsonpatienter är att de förlorade cellerna dels är av en enda sort och att de finns på ett avgränsat område i hjärnan. För stroke till exempel är det olika typer av celler som behöver ersättas, medans i ALS är det bara en enda celltyp som berörs, men där sitter de på olika ställen i hjärnan och längs ryggraden vilket gör det hela mycket mer komplicerat.
När finns behandlingen tillgänglig för alla Parkinsonpatienter?
– Nu gör vi denna första så kallade fas 1/2a-studie, det är en säkerhetsstudie med åtta patienter. Får vi bra utfall i dessa försök kommer vi att kunna gå vidare mot att utveckla ett läkemedel i samarbete med Novo Nordisk. Ska man vara realistisk så kan det nog ta upp emot tio år innan behandlingen finns ute på kliniken, dels för att vi ska igenom både fas 2 och 3 samt att effekten av att transplantera stamceller tar lång tid så varje fas blir väldigt utdragen.
Vilken roll har stödet från Hjärnfonden haft i att den här behandlingen kunnat tas fram?
– Stödet från Hjärnfonden har varit väldigt viktigt, framför allt i de tidiga experimentella studierna. Allt vi lär oss nu bygger på tidigare forskning där vi studerat hur nervcellerna byggs upp och fungerar i den plats i hjärnan där de ska utföra sin funktion. Vi startade upp de här studierna för tio år sedan så de resultat vi ser idag är ju egentligen inte ett genombrott, det är många genombrott under lång tid. En tidig milstolpe var när vi lyckades styra stamcellerna till exakt den celltyp vi vill ersätta. Vi behövde också förstå vad det är som gör att de ”kopplar upp sig” till det övriga nervsystemet och börjar fungera på sin nya plats. Teknikutvecklingen som görs nu är oerhört viktig för att vi ska kunna studera den biologiska utvecklingen av de här cellerna och hur de agerar.